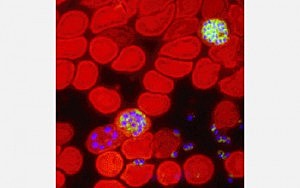
EL PRIMER HUMANO ADQUIRIO MALARIA HACE 2.5 MILLONES DE AÑOS

-
El Cólera es una diarrea infecciosa aguda producida por una bacteria Vibrio cholerae. La transmisión se produce predominantemente a través de agua o alimentos contaminados.
Heidelberg y col descubrieron la secuencia completa del material genético de la bacteria del cólera, el Vibrio cholerae.
"El genoma consiste en dos cromosomas circulares, de 2.961.146 y 1.072.314 pares de bases respectivamente", especifica la revista Nature. -
El Cólera es una diarrea infecciosa aguda producida por una bacteria Vibrio cholerae. La transmisión se produce predominantemente a través de agua o alimentos contaminados.
Heidelberg y col descubrieron la secuencia completa del material genético de la bacteria del cólera, el Vibrio cholerae.
"El genoma consiste en dos cromosomas circulares, de 2.961.146 y 1.072.314 pares de bases respectivamente", especifica la revista Nature.
referencia: http://www.nature.com/genomics/ -
Hartwell, Nurse y Hunt identificaron el mecanismo
básico del control de la división celular (proceso
por el cual se producen dos células de una única
célula) y mostraron que este mecanismo es común
a todos los organismos vivientes
Los trabajos de estos investigadores abrieron una nueva era en la
investigación en cáncer y nuevas posibilidades de
prevención, diagnóstico y terapia de estas
enfermedades.
Referencia: Nurse P,Masui Y, HariwellLUnderstandingthecell
cycle. Nature Medicine 1998 -
Un avance que, en su opinión, puede ser útil para combatir el problema que constituyen las bacterias resistentes a los antibióticos.
A partir de S.coelicolor y de los microorganismos de su familia se producen dos tercios de los antibióticos naturales existentes, entre ellos la tetraciclina y la eritromicina.Por ello, conocer en profundidad su genoma puede conducir al desarrollo de nuevos antibióticos y fármacos antitumorales
REFERENCIA: https://www.intramed.net/contenidover.asp?contenidoid=18749 -
El virus de la influenza aviar A(H5N1) altamente patógeno(HPAI) de origen asiático se da principalmente en aves y es sumamente contagioso.Desde noviembre del 2003, la OMS recibió informes de más de 700 casos de infección en seres humanos por los virus H5N1 HPAI de origen asiático provenientes principalmente de 15 países de Asia, África, el Pacífico, Europa y el Cercano Oriente. Hasta la fecha, Indonesia, Vietnam y Egipto.
Referencia: https://espanol.cdc.gov/flu/avianflu/h5n1-people.htm -
Formado por científicos de seis países descifraba, la secuencia completa (99,99%) del llamado libro de la vida: el genoma humano. Era la culminación del Proyecto Genoma Humano, que se había creado en 1990 para tal objetivo. En la larga cadena con forma de hélice que tiene el ADN se ocultan los miles de genes que contienen las instrucciones para el funcionamiento de un ser humano.
Referencia: https://www.fundacionaquae.org/ -
Es una enfermedad respiratoria causada por un tipo de bacteria llamado Legionella.
La Legionella se descubrió después de un brote ocurrido en 1976 entre las personas que fueron a una convención de la Legión Americana en Filadelfia. Las personas afectadas sufrieron de un tipo de neumonía (infección de los pulmones) que pasó a conocerse como la enfermedad de los legionarios.
Referencia: https://www.cdc.gov/legionella/about/history-sp.html -
Novel 2005. Lo recibieron dos científicos australianos que en 1982 probaron que el microorganismo Helicobacter pylori era el causante de serias enfermedades en el estómago como la gastritis y que los antibióticos resultan efectivos para el tratamiento de estas afecciones.
Referencia:https://www.intramed.net/contenidover.asp?contenidoID=37181#:~:text=Es%20el%20de%20Medicina%20y,serias%20enfermedades%20en%20el%20est%C3%B3mago. -
Estudios in vitro llevados a cabo en ratones, hurones y primates muestran que la cepa de referencia del virus (A/California/04/2009 [H1N1]) replica en éstos más eficientemente y causa lesiones patológicas en el pulmón más graves en los 3 modelos animales que distintas cepas del AH1N1 humano estacional
Referencia: https://www.elsevier.es/es-revista-enfermedades-infecciosas-microbiologia-clinica-28-articulo-infeccion-humanos-por-virus-gripe-S0213005X09005023 -
Es una micobacteria no tuberculosa (MNT), una agrupación que engloba todas las micobacterias fuera del complejo Mycobacterium tuberculosis. M fortuitum se clasifica en el grupo IV Runyon, micobacterias de crecimiento rápido. Se ha encontrado en las fuentes de agua naturales y procesados, así como en las aguas residuales y la suciedad. La distribución es probablemente todo el mundo.
Referencia: http://www.higiene.edu.uy/cefa/2008/micobacterias.pdf -
(también conocida como influenza porcina o gripe del cerdo)es una enfermedad infecciosa causada por cualquier virus perteneciente a la familia Orthomyxoviridae y es endémica en poblaciones porcinas
Es uno de los descendientes de la gripe española que causó una pandemia en la humanidad en el periodo1918–1919.Tras la finalización de la pandemia el virus persistió en cerdos,han circulado en seres humanos
Referencia:http://www.scielo.org.mx/scielo.php?script=sci_arttext&pid=S0188-252X2011000200005 -
Un equipo de científicos del Instituto Tecnológico de California (Caltech) ha publicado recientemente un artículo en la revista Nature en el que se describe cómo se producen los saltos evolutivos más radicales.
Los resultados de investigaciones realizadas con la bacteria Bacillus subtilis han vertido algo de luz en una gran cuestión pendiente sobre la evolución: cómo actúa ésta para que una especie pase de un estado fisiológico concreto a otro. -
Es una tecnología que permite que en 30 segundos se pueda determinar la presencia de microbios en un area en particular. Se trata de una tarjetaPRO Orion de Limpieza, una forma inusual de prueba química y la combinación de métodos innovadores para imprimir sobre superficies flexibles reacciones químicas sencillas.
Reerencia:https://universitam.com/academicos/noticias/desarrollan-tarjeta-detectora-de-microbios-y-baterias-se-podra-usar-en-hospitales-y-restaurantes/ -
Los científicos han determinado la escala de tiempo evolutivo de los parásitos microscópicos que causan una de las enfermedades más infecciosas y extendidas del mundo: la malaria.
Referencia:https://universitam.com/academicos/noticias/el-primer-humano-adquirio-malaria-hace-2-5-millones-de-anos/ -
Secretario de Energía de EEUU, premio Nobel y ex director del(Berkeley Lab), Steven Chu ha liderado el desarrollo de una técnica que permite el uso de la microscopía óptica para obtener la imagen de objetos tan pequeños del orden de 0,5 nanómetros, la magnitud más pequeña lograda hasta hoy en un microscopio óptico.
Referencia:https://universitam.com/academicos/noticias/secretario-de-energia-de-eeuu-logra-crear-microscopio-optico-con-resolucion-sub-nanometrica/ -
Un equipo de investigación dirigido por científicos del Instituto de Bioinformática de Virginia (VBI ) en la Universidad de Virginia Tech han descubierto un mecanismo fundamental que permite la entrada de peligrosos microbios y hongos que infectan a las plantas y causan enfermedades.
Referencia:https://universitam.com/academicos/noticias/los-cientificos-descubren-el-mecanismo-fundamental-que-permite-que-microbios-y-hongos-infecten-a-las-plantas/ -
se ha anunciado el esparcimiento en el mundo de un gen denominado «leche en polvo descremada 1» que da inmunidad contra los antibioticos a las llamadas enterobacterias como la E. coli y la Klebsiella pneumoniae haciéndolas resistentes a toda la poderosa línea de antibióticos carbapenémicos, dándose inicio así a la era del fin de los antibióticos.
Referencia: http://universitam.com/academicos/noticias/ha-llegado-el-fin-de-los-antibioticos-se-esparcen-en-el-mundo-bacterias-resistentes/ -
Un nuevo estudio co-escrito por el profesor Kam Tang, del Instituto de Ciencia Marina de Virginia revela que pequeños organismos acuáticos conocidos como «pulgas de agua» desempeñan un papel importante en el traslado de bacterias de un hábitats oceánicos a otro, normalmente inaccesible por otra vía.
Referencia:https://universitam.com/academicos/noticias/las-pulgas-mar-son-trasportadoras-de-bacterias-entre-habitats-oceanicos/ -
Un equipo con participación de científicos del CSIC ha detectado que los linfocitos T, un tipo de glóbulos blancos que reconoce moléculas de un patógeno (antígenos) y activa el sistema inmune, son capaces de “devorar” estas moléculas y de exponerlas a otros linfocitos T.
Referencia: https://universitam.com/academicos/noticias/descubren-que-los-linfocitos-t-detectan-moleculas-de-patogenos-y-las-devoran/ -
Hoy en día, un estudio internacional revela por primera vez que las bacterias que viven en asociación con mejillones hidrotermales son capaces de utilizar el hidrógeno como fuente de energía para producir materia orgánica.
Referencia: https://universitam.com/academicos/noticias/encuentran-bacterias-que-producen-energia-a-partir-del-hidrogeno-en-el-oceano/ -
Pseudomonas aeruginosa, es una bacteria ampliamente distribuida en la naturaleza.
El hallazgo excluye la posibilidad de emplear vacunas o algunos otros procedimientos higiénicos, porque “esas bacterias, que son potencialmente patógenas, van a estar en todas partes, por lo que habría que establecer otros mecanismos para tratar las infecciones”.
Referencia: https://universitam.com/academicos/noticias/buscan-en-la-unam-alternativas-para-infecciones-por-pseudomonas-aeruginosa/ -
Las bacerias intestinales no solo ayudan para mantener el instestino saludable sino que también envian mensajes al cerebro disminuyendo los niveles de ansiedad, miedo y estres, de acuerdo a una investigación realizada recientemente en ratones.
Referencia: http://universitam.com/academicos/noticias/las-bacterias-del-estomago-controlan-las-emociones-en-el-cerebro/ -
Los científicos quedaron sorprendidos al ver la rapidez con la que las bacterias se hacían resistentes a los antibióticos cuando estos fueron desarrollados hace menos de un siglo. Ahora, investigadores de la Universidad McMaster (Canadá) han descubierto que esta resistencia ya existía hace al menos 30.000 años.
Referencia: https://universitam.com/academicos/noticias/la-resistencia-a-los-antibioticos-por-las-bacterias-data-de-hace-30-mil-anos/ -
La bacteria Halomonas titanicae, un microorganismo encontrado en el casco del Titanic, es una de las diez especies del2011 del International Institute for Species Exploration de la Universidad de Arizona (EE UU).
El genoma completo de este microorganismo ha sido secuenciado en el (SGI) de Biología de la Universidad de Sevilla.
Referencia: https://universitam.com/academicos/noticias/la-bacteria-del-titanic-entra-al-top-de-las-10-nuevas-especies-recien-descubiertas/ -
Todos los que hemos tenido alguna inquietud científica hemos experimentado de pequeños con la llamada “tinta invisible”, que básicamente consistía en escribir un mensaje sobre un papel con jugo de cebolla o limón.
Manuel Palacios y su equipo de Tufts University han desarrollado un sistema que permite codificar información en el color de bacterias fluorescentes.
Referencia: https://universitam.com/academicos/noticias/cifran-mensajes-secretos-de-manera-facil-con-bacterias-e-coli/ -
Los cajones frigorífico de verduras y ensaladas puede contener 750 veces el nivel de bacterias considerado como seguro, advierten científicos. Se han encontrado ahí bacterias potencialmente mortales como la E. coli, salmonela y la listeria dijeron.
Referencia: https://universitam.com/academicos/noticias/encuentran-hasta-8-mil-bacterias-por-centimetro-cuadrado-en-los-refrigeradores/ -
Un gusano común en el este de Asia y Rusia causa en las personas cirrosis y cáncer. El gusano y su enfermedad se propagan en China, Corea, Japón. La clonorquiasis afecta a cerca de 35 millones de personas en el sudeste asiático y a 15 millones en China.
Referencia: https://universitam.com/academicos/noticias/un-gusano-comun-clonorchis-sinensis-ha-infectado-ya-a-50-millones-de-personas-en-rusia-china-japon-y-corea-debido-a-la-falta-de-genes-para-producir-acidos-grados/ -
El ARN codificante (que se traduce en proteínas) de más del 75% de los genes de la bacteria Staphylococcus aureus presenta regiones de solapamiento con ARN no codificante o con ARN codificante de genes adyacentes, según ha descubierto una investigación del Consejo Superior de Investigaciones Científicas (CSIC).
Referencia: https://universitam.com/academicos/noticias/descubren-un-mecanismo-de-digestion-con-solapamiento-de-arn-en-las-bacterias/ -
La reutilización de las pinzas ópticas como un nanomicrófono un millón de veces más sensible que el oído humano permite pensar que pronto tendremos un sistema para oír a las bacterias.
Referencia: https://universitam.com/academicos/noticias/logran-inventar-ya-el-nanomicrofono/ -
Descubren el primer animal que carece de centrosomas en las células de su cuerpo, algo que obliga a replantearse el papel de estos orgánulos en la división celular. Investigadores de la Universidad de California en San Francisco descubren que las planarias, o gusanos planos, no necesitan centrosomas en sus células.
Referencia: https://universitam.com/academicos/noticias/encuentran-primer-animal-sin-centrosomas-en-sus-celulas/ -
Una molécula incrustada en la membrana de las células del hígado humano que ayuda en la absorción de colesterol también permite la entrada de virus de hepatitis C, el primer paso en la infección por hepatitis C, según la investigación de la Universidad de Illinois en Chicago College of Medicine.
Referencia: https://universitam.com/academicos/noticias/receptor-del-colesterol-es-la-puerta-de-entrada-de-la-hepatitis-c/ -
nvestigadores del Instituto de Investigación del Sida IrsiCaixa y el Instituto de Ciencias Fotónicas (ICFO) han grabado por primera vez imágenes en vivo de cómo el VIH crea un ‘caballo de Troya’ para infectar rápidamente un organismo.
Referencia: https://universitam.com/academicos/noticias/captan-en-vivo-como-el-sida-vih-crea-un-caballo-de-troya-para-infectar-rapidamente-un-organismo/ -
Una bacteria que causa úlceras y cánceres estomacales podría proteger contra el asma mediante la enseñanza al organismo de la tolerancia del sistema inmune, según muestra un nuevo estudio en ratones.
Referencia: https://universitam.com/academicos/noticias/curioso-una-bacteria-estomacal-que-causa-cancer-cura-a-su-vez-el-asma/ -
Las proteínas son más que una necesidad dietética. Este conjunto diverso de moléculas participa en casi todas las operaciones celulares dentro de un organismo vivo. Los científicos pueden conocer la estructura de una proteína o de su función, pero no siempre han sido capaces de vincular los dos aspectos.
Referencia: https://universitam.com/academicos/noticias/descubren-la-relacion-entre-la-evolucion-de-las-proteinas-y-sus-funciones/ -
hora resulta que la resistencia a antibióticos no es un fenómeno moderno después de todo y sino que se remonta a por lo menos 1.000 años antes, en razón de que científicos descubrieron súper bacterias en los intestinos de las antiguas momias incas.
Referencia: https://universitam.com/academicos/noticias/encuentran-bacterias-resistentes-a-los-antibioticos-en-los-intestinos-de-momias-incas-de-hace-mil-anos/ -
Los científicos del Imperial College de Londres han descubierto una nueva manera de atacar la bacteria Staphylococcus aureus, al estudiar como esta regula sus niveles de sal para evitar ser deshidratada y morir.
Referencia: https://universitam.com/academicos/noticias/descubren-una-nueva-forma-de-matar-a-la-bacteria-staphylococcus-aureus-mediante-la-sal/ -
La biología sintética permite a los científicos diseñar circuitos genéticos que se pueden colocar en las células, dándoles nuevas funciones como la producción de fármacos u otras moléculas útiles. Sin embargo, a medida que estos circuitos se hacen más complejos, los componentes genéticos pueden interferir unos con otros, dificultando el logro de funciones más complicadas. https://universitam.com/academicos/noticias/investigadores-del-mit-crean-celulas-sinteticas-para-aislar-circuitos-geneticos/
-
Los investigadores han descubierto microorganismos no identificados previamente que tienen un elemento genético que les permite auto-mutar. Lo que es más, estos organismos son tan abundantes que expanden considerablemente la diversidad del árbol de la vida.
Referencia: http://universitam.com/academicos/noticias/descubren-microorganismos-que-auto-mutan-mas-pequenos-que-bacterias-y-abundantes-en-el-planeta/ -
Un equipo científico ha descubierto la bacteria Thiolava veneris en el volcán submarino Tagoro, que se creó a raíz de la erupción volcánica en la isla canaria de El Hierro, entre finales de 2011 e inicios de 2012.
Referencia: https://universitam.com/academicos/noticias/emerge-nueva-bacteria-luego-de-erupcion-del-volcan-submarino-tagoto/ -
Los probióticos, bacterias vivas y levaduras, no se han estudiado lo suficiente para decir si previenen enfermedades, problemas autoinmunes o alergias. Pero la popularidad de los probióticos está enraizada en algo real: la salud intestinal está fuertemente relacionada con la salud general.
Referencia: https://universitam.com/academicos/noticias/el-trasplante-del-microbiomas-intestinal-de-una-persona-a-otra-transfiere-enfermedades-y-salud-el-trasplante-fecal-popo-ayuda-contra-las-superbacterias/ -
El coronavirus humano más conocido era el SARS-CoV, un virus que infecta el tracto respiratorio tanto en su parte superior como inferior y fue identificado por primera vez a finales de febrero de 2003 tras el brote del(SARS)en Asia. Nueva enfermedad a partir de un virus se convirtió en pandemia
Referencia:https://www.portalfarma.com/Profesionales/campanaspf/Asesoramiento-salud-publica/infeccion-coronavirus-2019-nCoV/Documents/Informe-tecnico-Coronavirus.pdf
Looking for a timeline maker?
Create timelines for projects, roadmaps, history, lessons, legal cases, and stories with Timetoast. Timetoast is a timeline maker for work, school, research, and stories.